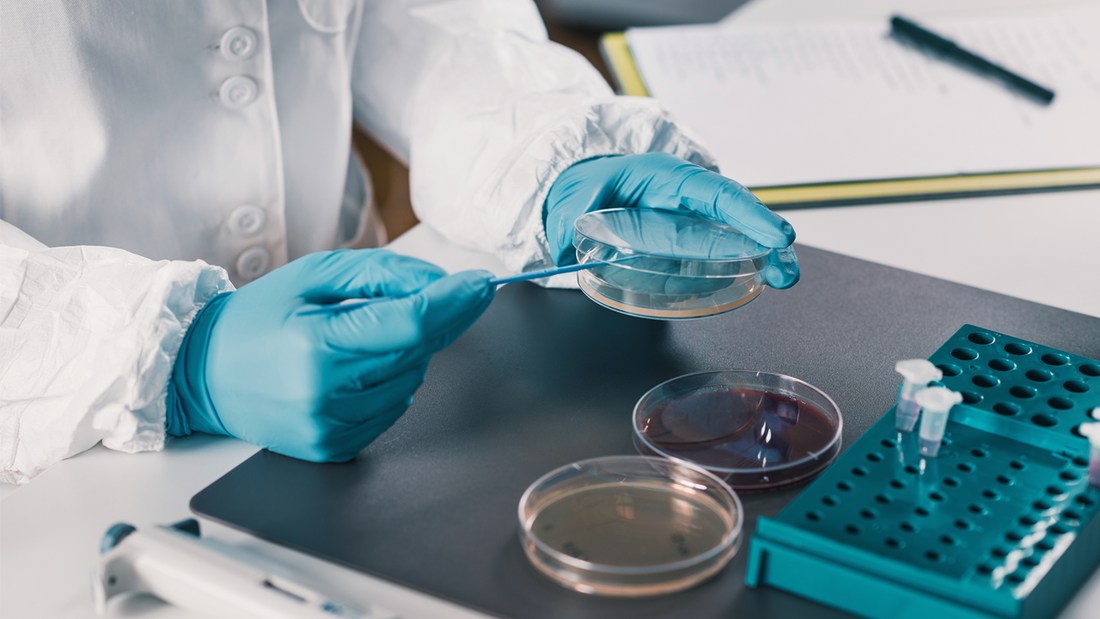
The ultimate guide to selecting cosmetic preservatives

The preservation of cosmetic products against microbial contamination ensures consumer safety and increases shelf life. It can be challenging to choose the right preservative for your cosmetic formulation among a wide variety of synthetic and natural preservatives.
With so many choices in preservatives, and lots of misinformation on the internet, how can you make the Perfect Preservative Selection?
Regardless of the formulation type, company/product philosophy, or product type, no one preservative can satisfy all needs. Technically, any preservative that meets the requirements of regulators in the region and is appropriate for the product type and end consumer should be used.
Below is a list of some key elements that need to be considered before selecting the preservative:
Company/ Product Philosophy
It is important to make your selection based on the company and/or product philosophies, particularly if they claim to be 'natural' or 'avoid' certain ingredients or if organic certification is required. These claims play an important role in preservative selection.
Regulatory Considerations
For use in any personal care product, your preservatives must be:
Permitted in the countries where it will be sold to the end consumer, and
Under any conditions or limits stipulated.
The limits of most preservatives, for example, are very specific, and can only be used within those limits.
The use of other preservatives may be governed by very specific conditions, such as not being used on mucous membranes or only in wash-off products. To ensure regulatory compliance with the finished product, conditions of use must be followed.
Safety evaluations have generally guided the limits and conditions of use set by regulators. Hence, the use of preservatives following the regulations is not only a legal requirement but also an important safety consideration to ensure a finished product's safety.
Product Form
A product's form will be the next big deciding factor, affecting preservative selection based on:
Transparency of the finished product is also quite essential.
Dispersibility or solubility of the preservative
Preservatives must be uniformly distributed throughout a large vat to ensure a product is adequately preserved.
Chemical nature of the product
Some preservatives cannot be used in charged environments (anionic or cationic), while others may be more effective.
Materials used in the formulation and their Microbial Risk Classification (MRC)
Materials with higher-risk ingredients will need stronger-acting preservatives; this does not mean one should ‘over preserve’ a product; rather, careful selection is necessary to ensure broad-spectrum coverage, a synergy of blends to ensure adequate microbial protection.
Compatibility and Stability
It is not easy to select an active antimicrobial molecule that can act as a preservative. A good preservative should have a good O/W partition coefficient since this will enhance its activity in the aqueous phase. An external factor, such as pH or manufacturing process, should not inactivate it. To prevent any adaptation or resistance to the preservative, the preservative should sufficiently inactivate microorganisms quickly.
Preservative stability can be affected by several factors, including solubility and partition in oil/water (O/W) or water/oil (W/O) emulsions, formulation pH, temperature during use, and volatility. Additionally, a preservative must be compatible with other components of a cosmetic formulation, such as surfactants, solvents, pigments, fragrances, and other ingredients.
For each formula, an ideal preservative system must be selected, taking into account possible inactivating ingredients or potentiating ingredients.
Additionally, packaging plays a role in influencing preservative activity, adsorption rate on some formula components, the solubility of the preservative molecule, and volatility. It is also important to ensure physical compatibility as well. To preserve the cosmetic product's appearance, the preservative must be tasteless, odorless, and colorless.
SBBLG is the leading manufacturer of aroma chemicals and other synthetic chemicals which can be used in different industries including pesticides. Get the best Pesticide agent manufacturer and fungicide agent manufacturer. Visit the SBBLG website for more information.